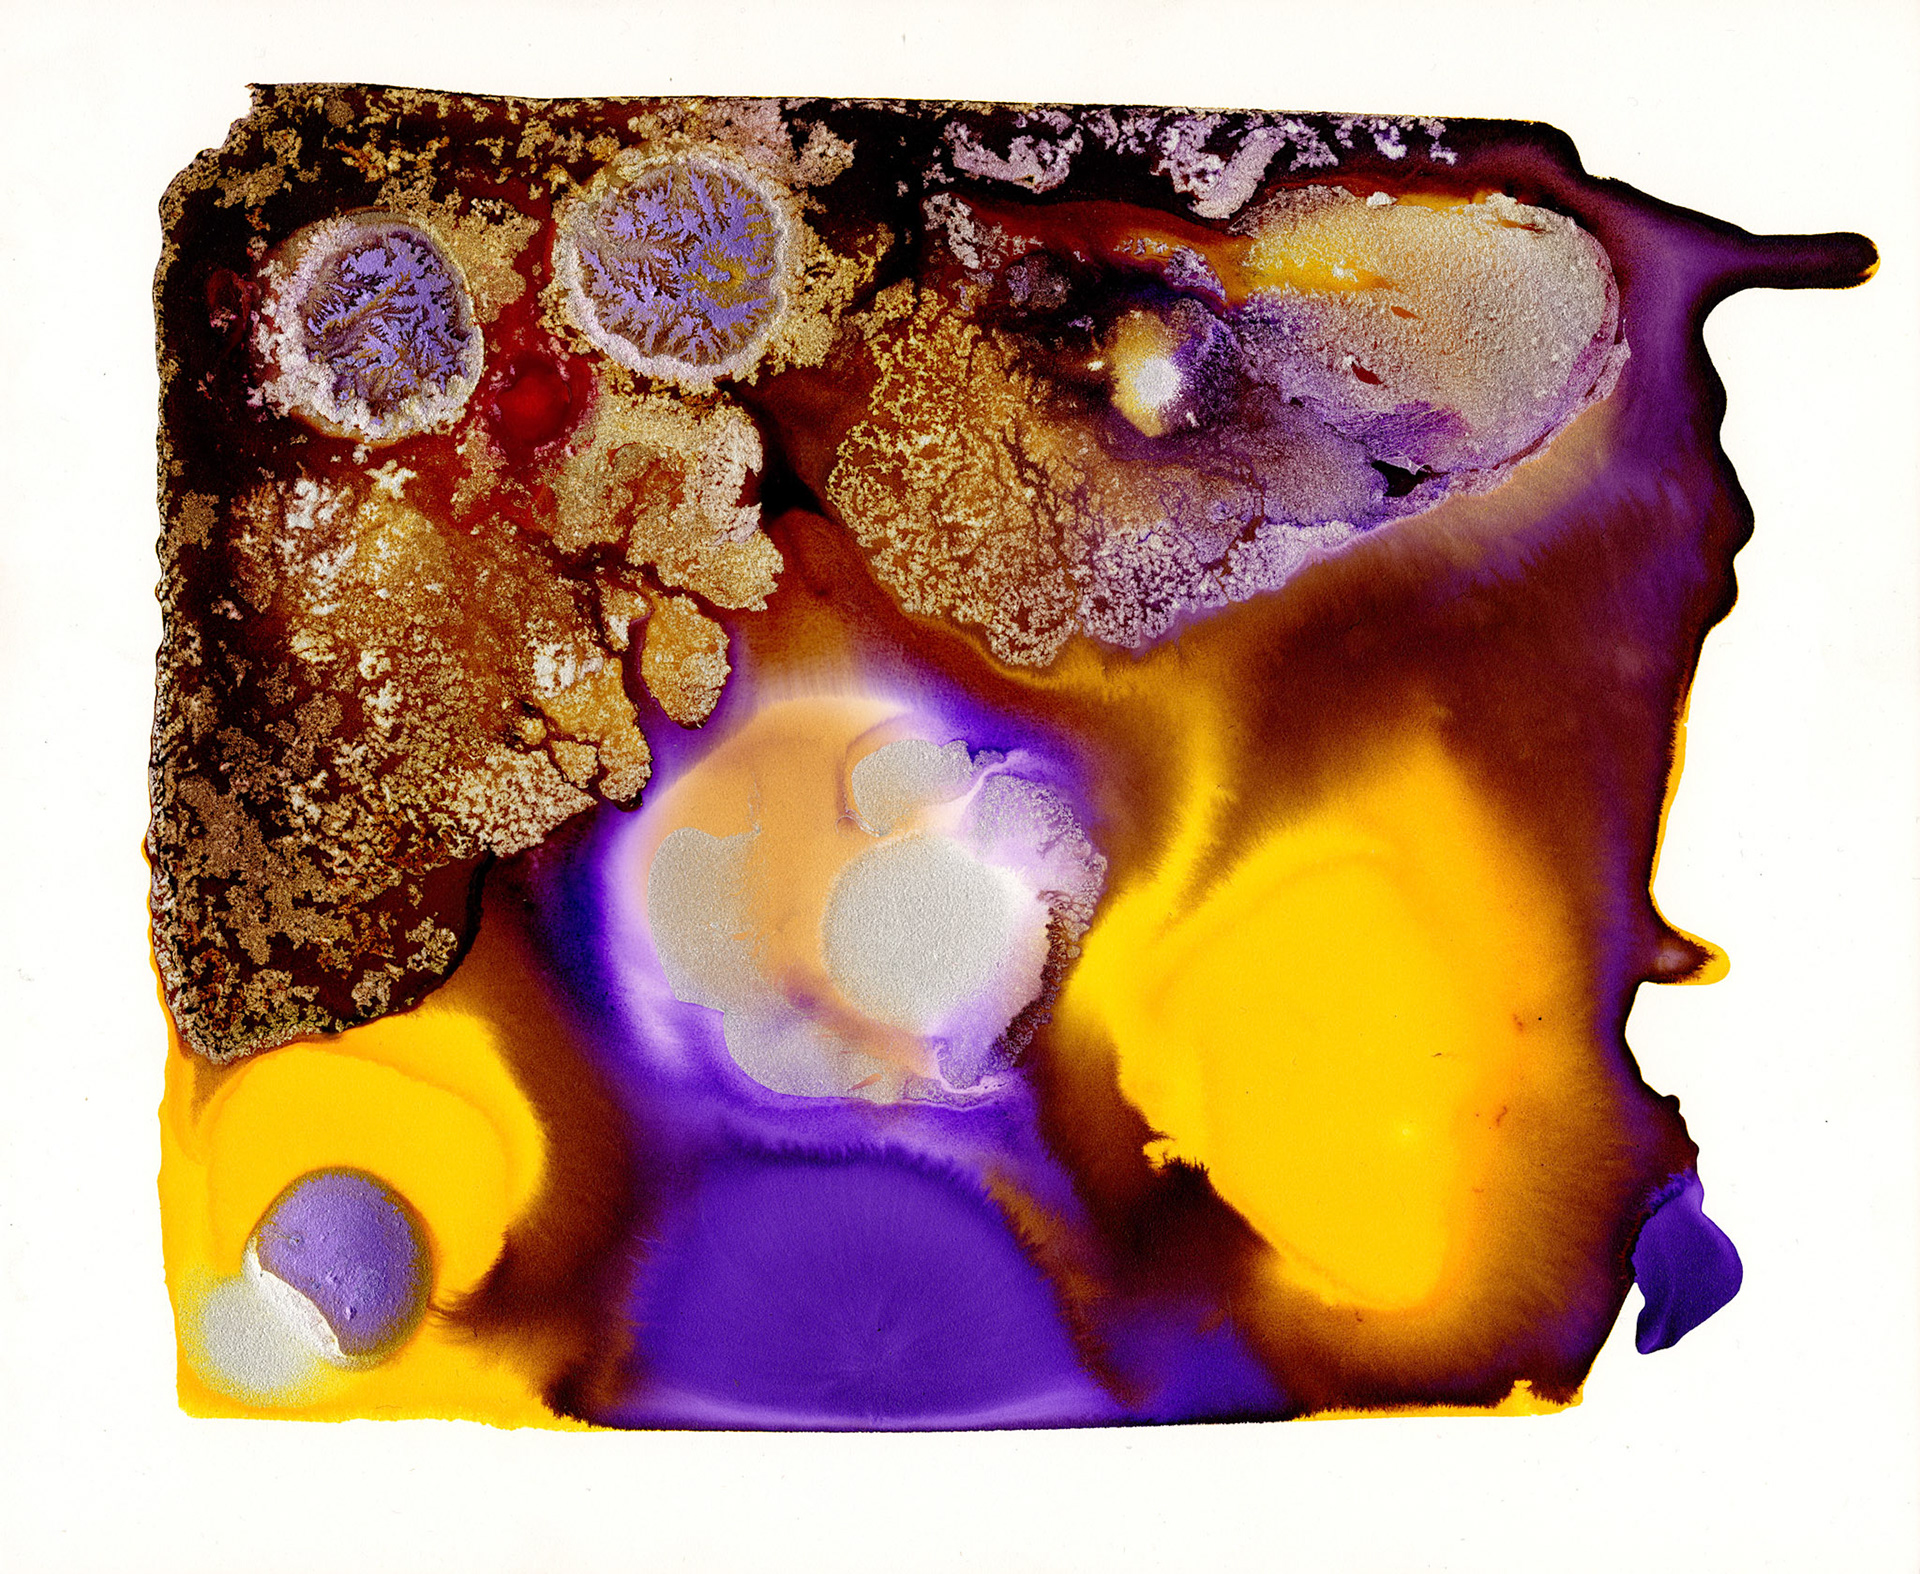

These abstract paintings are part of a series that explore light, texture, the natural flow of paint and merging forms. Since they are painted on blocks, these blocks can be pieced together to form a larger work and also be rearranged so the work remains fluid and organic. Many of these paintings were part of a commission for the Clifton Hotel group in Bristol, which hangs over one hundred of Sanchita’s paintings. They try to resemble nature in their natural equilibrium, which is achieved precisely because these paintings allow the paint to do most of the work, with just a gently nudge of the hand and a watchful eye. Medium: Acrylic ink / Size: A4 - A0 / Date: 2002 - 2008